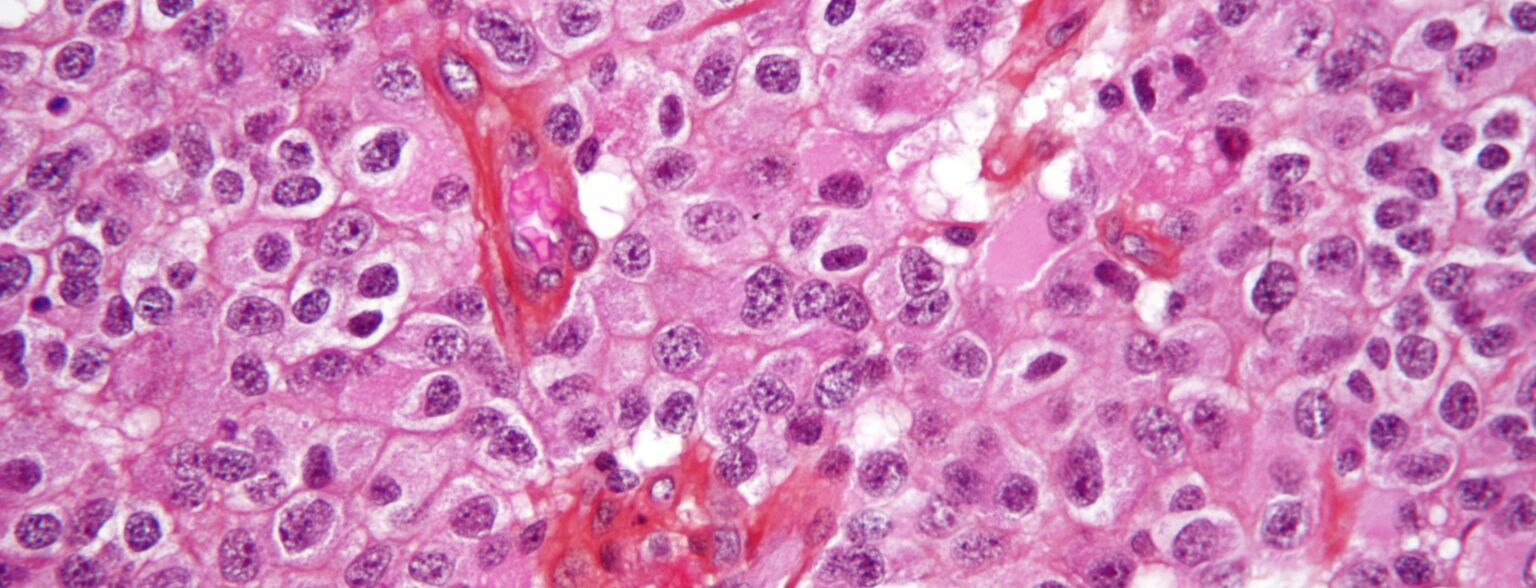
Oligodendroglioma1 high mag e1422819141813 أسباب الإصابة بمرض السرطان مجلة نقطة العلمية

ربما سيختلف العلماء في تسمية مسبب السرطان الأول لدى البشر، حيث سيذهب بعضهم إلى القول بأن السبب الأساسي للإصابة بالسرطان هو نوع الحياة التي نعيشها، وعاداتنا السيئة التي قد تتسبب في السرطان كالتدخين مثلاً، بينما سيذهب البعض الآخر الى القول بأن العامل الجيني والوراثي هو المسبب الأهم، وإن احتمال إصابتك بالسرطان تتزايد كلما كان لعائلتك تاريخ ما مع المرض الخبيث. إلا أنه في بحث أخير توصل العلماء بجامعة جون هوبكنز الأمريكية إلى أن المسبب الأخطر على الاطلاق للسرطان هو “الحظ السيء”!
أجل فالحظ السيء ليس التدخين أو قلة ممارسة الرياضة ولا حتى حظك السيء مع تاريخ عائلتك الحافل بالمرض. حيث وجد العلماء أن أكثر من ثلثي الاصابات بالسرطان التي يصاب بها البشر تكون بسبب أخطاء عشوائية تماما في انقسام الخلايا بمعنى آخر ذلك الأمر خارج عن سيطرتنا تماماً.
الباحثون وجدوا أنه كلما زادت نسبة انقسام الخلايا في الجسم للمحافظة عليه في صحة جيدة، كلما ازدادت فرص تعرض ذلك الجسم للإصابة بالسرطان.
هذا البحث الجديد هو الأول على الاطلاق الذي يجيب على سؤال لماذا بعض أنواع السرطانات أكثر شيوعا من غيرها.
فمثلا لماذا تكثر الإصابة بسرطان القولون عن سرطان الأمعاء الدقيقة؟ وفقا للبحث فإن ذلك يرجع إلى أن خلايا القولون تنقسم أسرع من خلايا الأمعاء الدقيقة بحوالي الضعف تقريباً.
البحث الذي تناولت 33 حالة مصابة بالسرطان وجد أن 9 اصابات فقط بين ال33 كانت لهم علاقة بنمط الحياة أو الأخطاء الوراثية، بينما كانت باقي الاصابات -22 إصابة- مجرد نتيجة للحظ السيء كما قال القائمون على البحث.
النتيجة الجديدة التي تعنى أن الوقاية من السرطان لن تكون من خلال تغيير نمط الحياة أو الفحص الجيني فقط، بل لابد أن تبذل المزيد من الجهود للتوصل إلى طريقة عملية وسريعة لتشخيص المرض وبالتالي رصده في وقت مبكر على قدر المستطاع، مما يعطي الأطباء فرصة أكبر في محاربته.
وقال الدكتور كريستسان توماسيتى، الأستاذ المساعد بقسم الأورام في جامعة جون هوبكنز، أن تلك النسبة (نسبة الثلثين) إذا كانت من نصيب العامل الوراثي أو النمط الحياتي لكانت النتيجة التي خلص إليها البحث أن نقوم بتغيير أنماط حياتنا، والتوقف عن العادات السيئة، أو حتى نقوم بعمل فحوصات جينية للتأكد والوقاية، إلا أن النسبة كانت من نصيب الانقسامات العشوائية للخلايا وبالتالي، يجب أن يتجه البحث الآن بشكل مكثف نحو ايجاد طرق للكشف عن مثل تلك السرطانات في وقت مبكر أي في مراحله التي يكون فيها قابلا للعلاج.